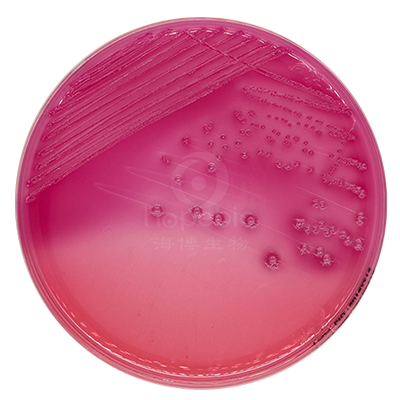
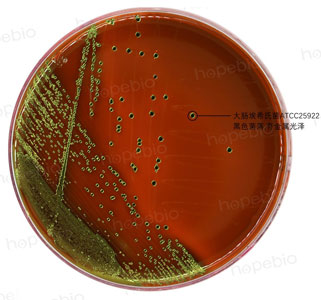

海博微信公众号
海博微信公众号
 海博天猫旗舰店
海博天猫旗舰店


 海博微信公众号
海博微信公众号
 海博天猫旗舰店
海博天猫旗舰店




一、大肠埃希氏菌简介
大肠埃希氏菌(Staphylococcus aureus)是隶属于埃希氏菌属的一种常见的菌株,革兰氏染色为阴性杆菌,两端呈钝圆形,直径约0.5μm,生化代谢非常活跃,发酵葡萄糖产酸、产气,个别菌株不产气,大肠杆菌还能发酵多种碳水化合物,也可以利用多种有机酸盐,是人和动物肠道中的正常栖居菌,某些血清型的大肠杆菌在一定条件下可以引起人和多种动物发生胃肠道感染或尿道等多种局部组织器官感染。
二、活化方法
培养基的选择:大肠埃希氏菌的生命力强,易存活,对营养要求不高,常用的非选择性培养基大多数都可以用来对大肠埃希氏菌活化及传代,如营养肉汤/琼脂、胰蛋白胨大豆肉汤/琼脂、脑心浸液肉汤/琼脂等。
注:对菌种进行活化和传代时,通常不使用麦康凯琼脂、VRBA琼脂、EE肉汤等选择性培养基。
操作方法:若菌种为冻干粉形式,按照说明书溶解后,可直接涂布或划线至NA/TSA/BHI平板上,也可加入至NB/TSB/BHI等液体培养基中;若菌种为甘油冻存管形式,从冰箱中取出速融后,NA/TSA/BHI平板上,也可加入至NB/TSB/BHI等液体培养基中;若菌种为瓷珠形式,挑取瓷珠可转入NA/TSA/BHI平板上,也可加入至NB/TSB/BHI等液体培养基中,30-37℃培养18-24h。
三、实验室常用保存方法
1.斜面保存法
将NA/TSA/BHI等培养基制成斜面管,接种大肠埃希氏菌后培养至菌落生长良好,置于2-8℃可保存至少1个月,超过1个月容易出现菌种老化、污染、变异等现象,建议及时传代。
2.脱脂牛奶/甘油/瓷珠冷冻保存法
可挑取非选择性培养基上培养好的大肠埃希氏菌至脱脂牛奶/液体/瓷珠菌种保存管中制成约109CFU/mL的菌液(瓷珠保存法需摇匀后弃菌液保留瓷珠),置于冰箱或液氮罐中冷冻保存,在-70℃以下可保存两年以上,在-20℃也能保存一年以上,大肠埃希氏菌生命力强,很容易保存数年或数十年。
四、菌种的确认
1.菌落特征:大肠埃希氏菌麦康凯平板上由于发酵乳糖产酸,菌落呈粉红色,并在菌落周围出现胆盐沉淀的浑浊圈。在EMB琼脂上发酵乳糖产酸,形成具黑色中心有绿色金属光泽的菌落
|
|
|
麦康凯平板 |
EMB平板 |
2.革兰氏染色:大肠埃希氏菌菌为革兰氏阴性无芽孢杆菌,短杆菌,两端呈钝圆形。

3.生化特性:大肠埃希氏菌可在44.5℃下发酵乳糖产酸产气。

乳糖蛋白胨培养液
4.IMViC试验:此实验可用做大肠埃希氏菌的确证试验。

大肠埃希氏菌与非大肠埃希氏菌的生化鉴别:

注:本文属海博生物原创,未经允许不得转载。
下一篇:实验室常用菌株安全级别介绍



